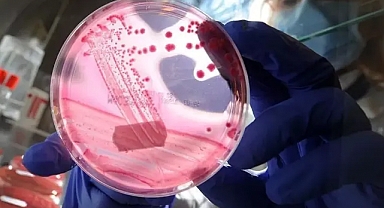

Obeziteye yol açan beslenme alışkanlıklarının, meme kanseri riskini artırdığını belirten Medicana Sağlık Grubu Medikal Onkoloji Bölümü’nden Doç. Dr. Nalan Akgül Babacan, Akdeniz tipi beslenmenin de meme kanseri riskini azaltmada faydalı olabileceğini söyleyerek bu hastalık hakkında bilgi verdi.Günümüzde her 8 kadından 1’inde meme kanseri görülebildiğini söyleyen Medicana Zincirlikuyu Hastanesi Medikal Onkoloji Uzmanı Doç. Dr. Nalan Akgül Babacan, “Menopoz sonrası kadınlarda daha sık gözlenmekle birlikte, genç yaşta tanı alan kadınların sayısı da azımsanamayacak düzeydedir; vakaların yaklaşık yüzde 16’sı 50 yaşın altındadır. Bunun ötesinde, 2012’den beri her yıl hastalığın insidansında, belli bir zamanda, her 100 bin kişide yeni tanı almış hasta sayısında yüzde 1’lik bir artışın da gözlendiğini bildiren çalışmalar mevcut. Bu artışın nedenleri arasında erken tanı olanaklarının artması (mamografi, MR, tarama programları), kadınların yaşam tarzı değişiklikleri (geç doğum, doğurmama, kısa süreli emzirme), obezite ve metabolik sendromun yaygınlaşması, çevresel faktörler ve endokrin bozucu kimyasalların (plastik, kozmetik, tarım ilacı kalıntıları vs.) daha fazla maruz kalınması bulunmaktadır” dedi.‘YUMURTALIK VE FARKLI KANSER TÜRLERİYLE İLİŞKİLİ’Meme kanserinin başka kanserlerle bağlantılı olduğuna değinen Doç. Dr. Babacan, “Hem genetik hem de epigenetik düzeyde bazı kanserler birbiriyle bağlantılı olabilir. Burada aklımıza ilk olarak ailesel kanser sendromları gelmektedir. Örneğin, aktrist Angelina Jolie’nin de taşıyıcı olmasıyla ünlenen BRCA1 ve BRCA2 gen mutasyonları taşıyan bireylerde sadece meme kanseri değil, over (yumurtalık), pankreas ve prostat kanseri riski de belirgin artmaktadır. TP53 gibi tümör baskılayıcı genlerdeki mutasyonlar, meme kanserinin yanı sıra beyin tümörleri, sarkomlar ve lösemilerle ilişkili olabilir. Ailesinde kolon, over veya meme kanseri öyküsü bulunan bireylerde ailesel kanser sendromları göz önünde bulundurulmalıdır” diye konuştu.‘KÖTÜ BESLENME, RİSKİ ARTIRIYOR’Kötü beslenme alışkanlıklarının meme kanseri riskini artırabileceğine değinen Doç. Dr. Babacan, “Özellikle yüksek glisemik indeksli gıdalar, işlenmiş et ürünleri, aşırı hayvansal yağ, şekerli ve gazlı içecekler ile obeziteye yol açan beslenme alışkanlıkları, meme kanseri riskini artırmaktadır. Yağ dokusu, menopoz sonrası östrojenin ana kaynağıdır. Östrojenin fazla olması özellikle hormon pozitif meme kanserleri için bir risk faktörüdür. İnsülin direnci ve hiperinsülinemi, hem hücresel proliferasyonu artırır hem de tümör mikro çevresini kanserleşmeye daha yatkın hale getirir. Kronik iltihabi süreç, kötü beslenme ile birleştiğinde bağışıklık sistemini zayıflatarak tümör gelişimini kolaylaştırır. Dolayısıyla Akdeniz tipi diyet, sebze ve meyve ağırlıklı beslenme, zeytinyağı kullanımı, rafine karbonhidrattan uzak durma gibi yaklaşımlar koruyucu olabilir” ifadelerini kullandı.‘RİSK FAKTÖRLERİNİ ÖNLEMEK TEDAVİ KADAR DEĞERLİ’Tüm kanserlerde olduğu gibi meme kanserinde de temel prensibin, "Erken tanı hayat kurtarır" olduğunu söyleyen Doç. Dr. Babacan, “Ancak sadece erken tanı değil, risk faktörlerinin önlenmesi de en az tedavi kadar değerlidir. Bu nedenle toplumda farkındalık yaratmak, beslenme ve yaşam tarzı üzerine bilinç oluşturmak en büyük önceliğimiz olmalıdır. Her kadının 40 yaş sonrası düzenli tarama mamografi, ultrason yaptırması, aile öyküsü olanların varsa genetik danışmanlık alması erken teşhiste önemlidir. Bunun yanında beden kitle indeksini korumak, düzenli egzersiz yapmak, kırmızı et, rafine şeker ve hazır gıdaları sınırlamak, alkol ve sigaradan uzak durmak koruyucudur. Şüpheli kitlelerde geç kalmadan doktora başvurmak da hayati önem taşımaktadır” dedi. (DHA)
SAĞLIK
Yayınlanma: 11 Ekim 2025 - 08:02
Meme kanserine karşı Akdeniz tipi diyetle beslenin
DÜNYA Sağlık Örgütü (WHO) ve Uluslararası Kanser Araştırma Ajansı (IARC) verilerine göre, kadınlarda en sık görülen kanser türü olan meme kanseri vakaları dünya nüfusu arttıkça, göreceli olarak meme kanserli hasta sayısı da yükseliyor.
SAĞLIK
11 Ekim 2025 - 08:02